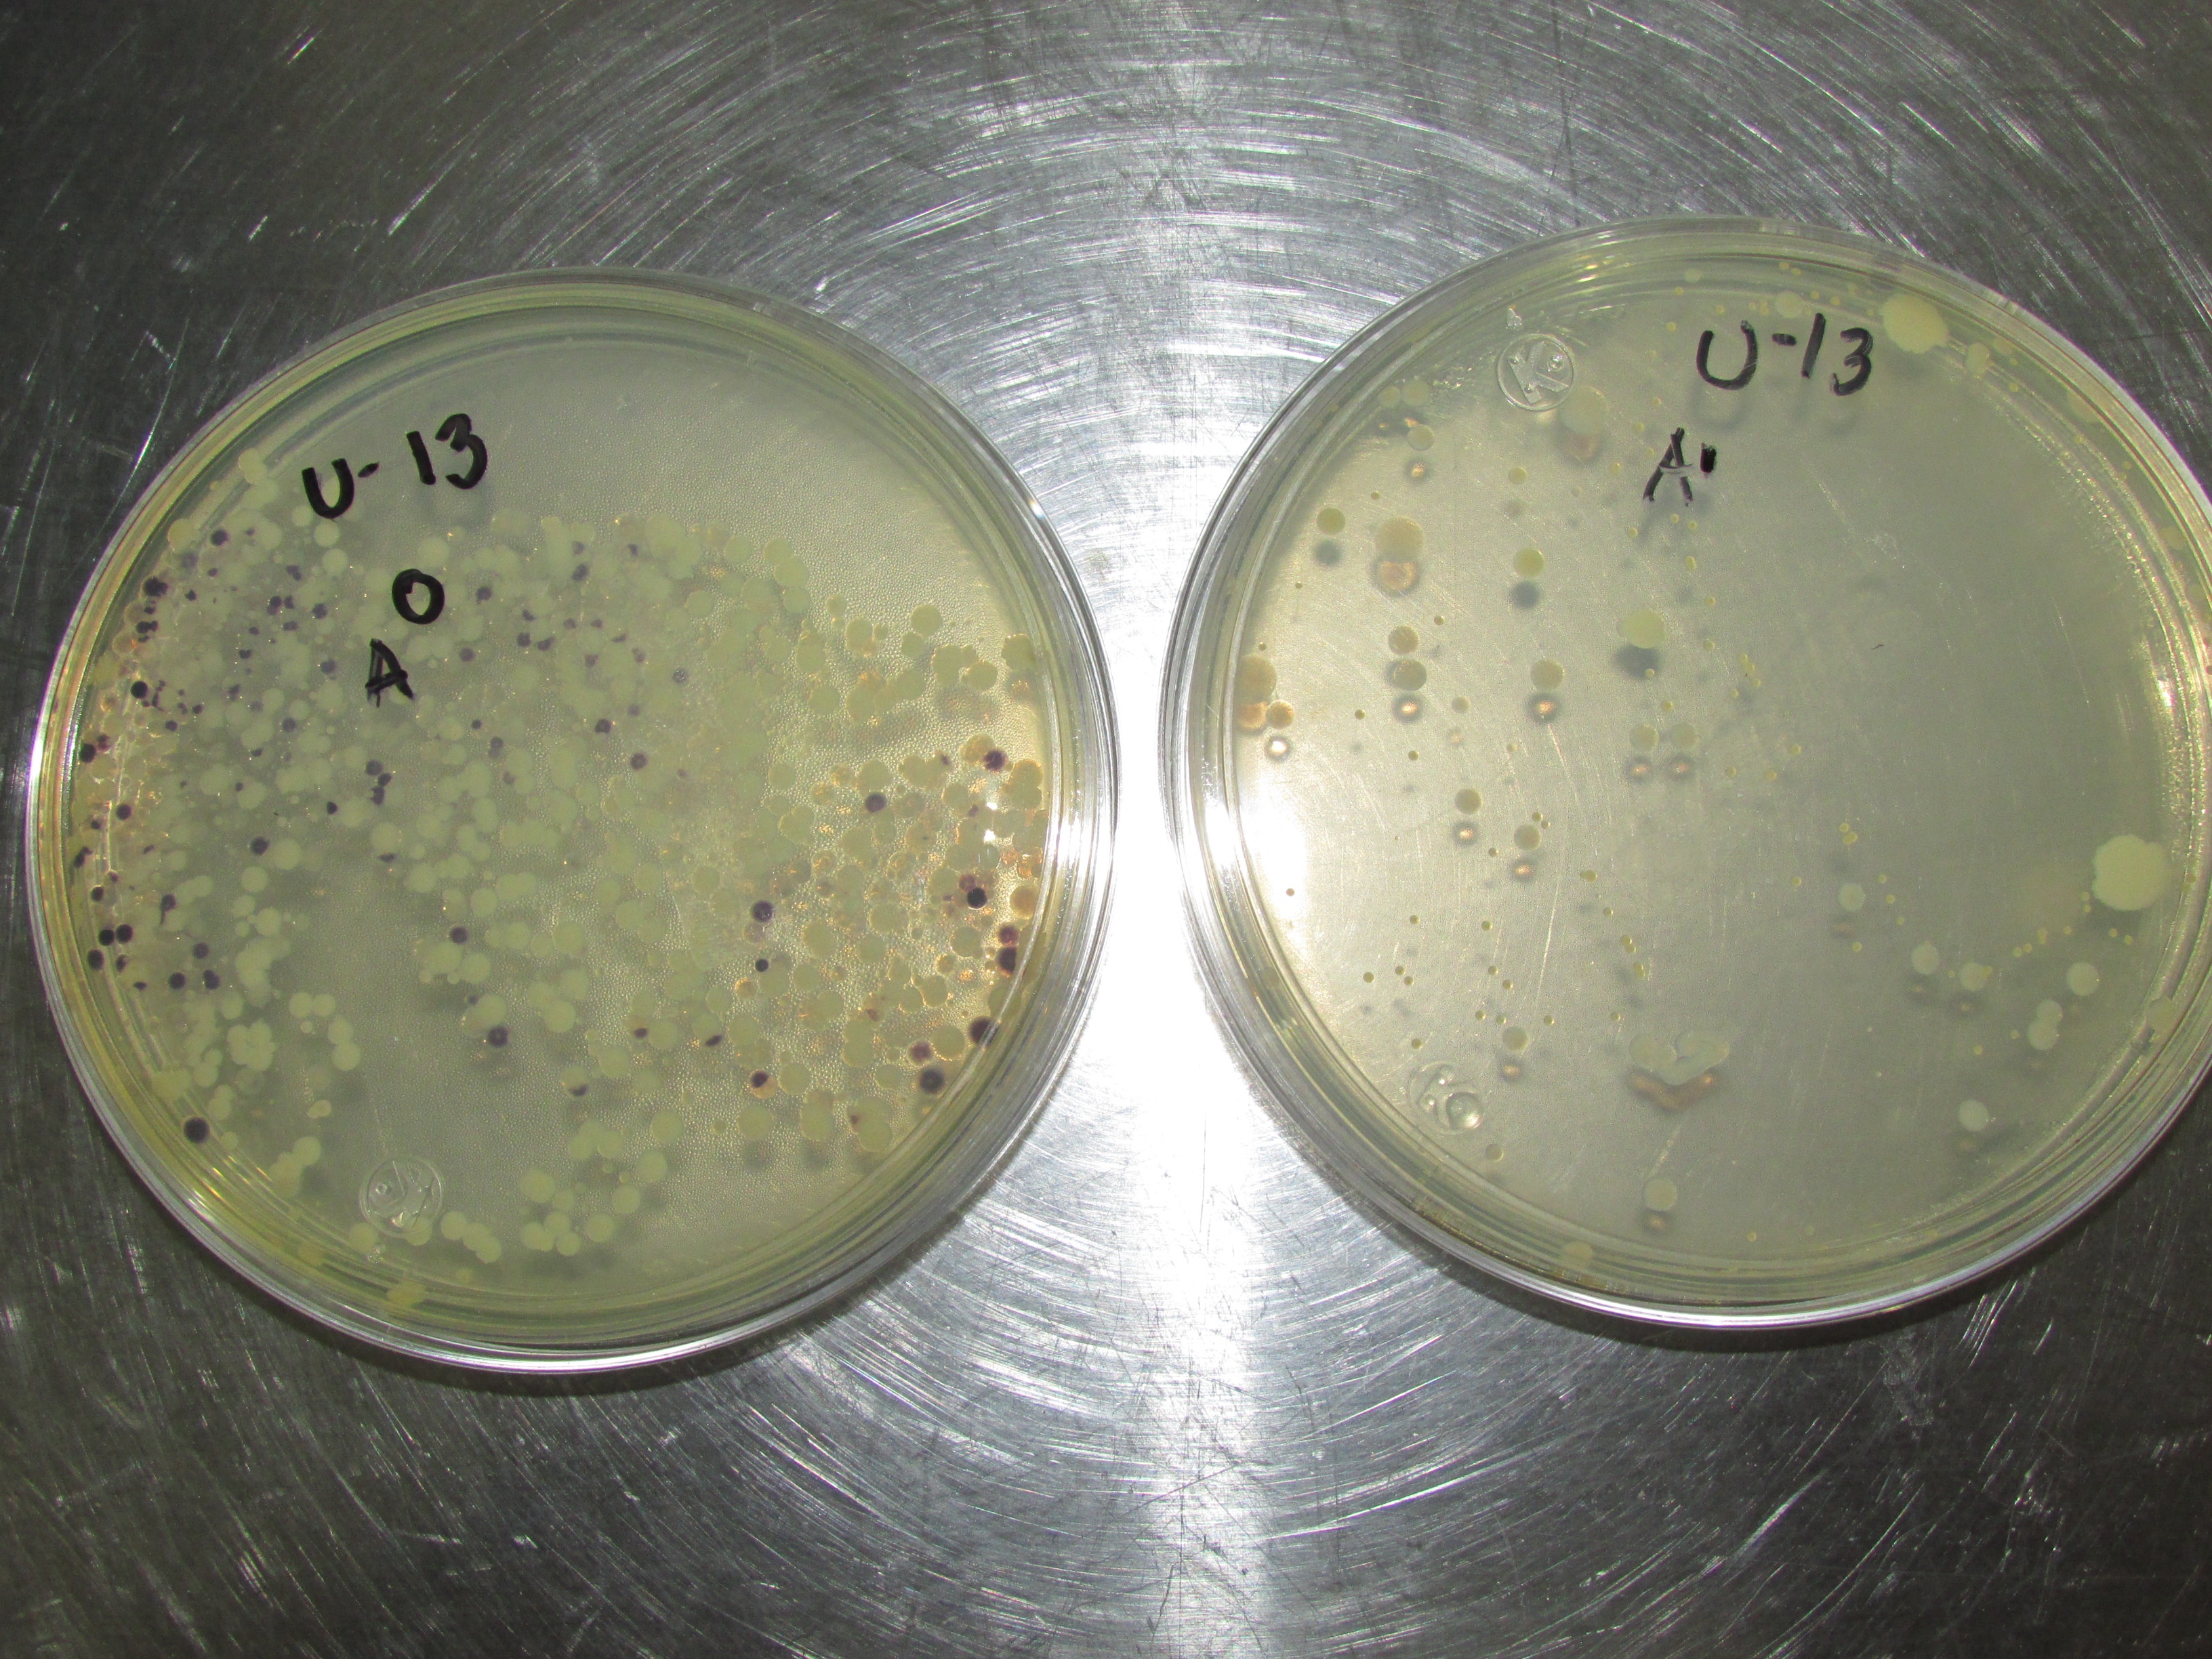
https://0201.nccdn.net/1_2/000/000/0f9/94f/IMG_4385-3264x2448.jpg

Argon Química es una empresa especializada en la fabricación, venta y aplicación de productos químicos para el tratamiento de aguas. Nuestra experiencia de 27 años en la fabricación y aplicación de productos químicos en la industria nos respaldan.
Algunos de los productos químicos que ofrecemos a la industria son:
| |